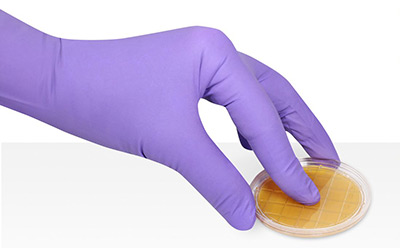
接触平板法进行微生物表面与人员监测

表面与人员检测
表面检测与人员检测是用于采集、检测和表征各类微生物水平的方法,旨在监测关键与非关键生产区域消毒流程的有效性。 生产环境的卫生标准直接关系到成品的微生物安全与质量。为保障消费者权益,多个政府机构制定了相关规范方法,包括欧盟cGMP、美国FDA无菌操作指南及USP<1116>等标准,这些规范适用于制药、化妆品、食品和饮料等行业的监管。
精选分类
传统表面监测
为确保产品安全,必须监测生产区域(如工作台、墙壁、门等)以及隔离器和洁净室内的表面洁净度。这些表面和区域必须无微生物污染,以减少交叉污染风险,否则可能导致产品使用或食用不安全。
无菌及受控环境需通过表面采样方法进行高频监测。平面采样时,将接触板或载玻片以均匀稳定的压力按压表面数秒,随后将样本板或载玻片培养以促进微生物生长,最后对培养出的细菌菌落进行计数。培养条件需根据微生物群落组成及法规要求调整。曲面及难以触及区域可采用拭子检测法进行监测。
快速表面监测
需要快速结果的生产商可采用快速方法量化消毒后、操作前的微生物残留。此类方法包括无需仪器的比色法检测,或需配合发光计等仪器读取的采样拭子检测。食品饮料行业对快速质量控制方法的需求尤为迫切——既因其产品易腐特性,也为满足其他行业日益增长的生产需求。
人员监测
人员监测旨在确保无菌环境的维持。设施内绝大多数污染源可追溯至洁净室工作人员。人员进出无菌洁净室前,必须严格遵循特定的穿戴防护服及灭菌程序。
相关文章
- Explore our range of contact plates and swabs for microbiological testing. Ideal for environmental monitoring in cleanrooms and controlled areas, our products ensure reliable surface and personnel testing to minimize contamination risks.
- ICR 拭子是一种拭子系统,用于对各种干燥表面进行环境监测,如填充针、设备凹槽、不平整表面以及洁净室和隔离器中的管道。
- The ICR swabs and ICR contact plates are designed for environmental monitoring i.e., detection and enumeration of microbial contamination on dry, flat, and hard-to-access surfaces in cleanrooms and isolators.
- Microbial monitoring; environmental monitoring; interim storage; ICR contact plates; contact plates; TSA w. LTHThio Contact ICR+
- IsoBag® ease the environmental monitoring workflow in aseptic production isolator
- 查看全部 (5)
查找更多文章和协议
如何提供帮助
如有任何疑问,请提交客户支持请求
或联系我们的客服团队:
发送邮件至 custserv@sial.com
或致电 +1 (800) 244-1173
额外支持
- 计算器与应用_缓冲液计算器_HPLC方法转换计算器-默克生命科学
默克该工具箱包括用于化学、生命科学、材料科学等方面的科学研究工具和资源。
- Customer Support Request
Customer support including help with orders, products, accounts, and website technical issues.
- FAQ
Explore our Frequently Asked Questions for answers to commonly asked questions about our products and services.
如要继续阅读,请登录或创建帐户。
暂无帐户?



